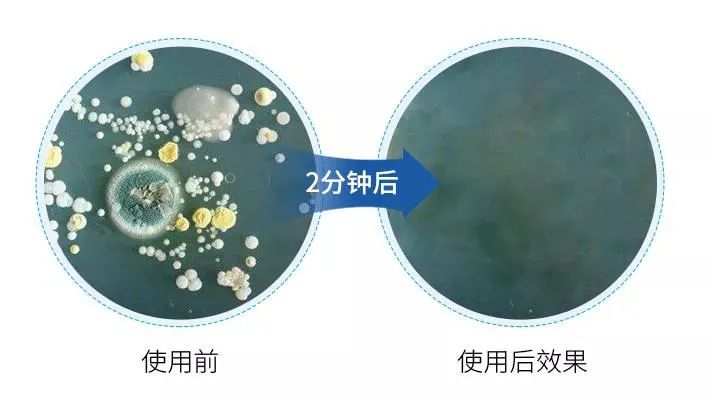

这辈子得啥也别得“痔疮”
太痛苦了!
每次一犯
像是有人拿着电钻在捅屁股
那滋味儿真折磨人...

站不直、坐不下
碰一下疼的要命
还偏偏不好意思和别人说

痔疮长在外面的叫外痔
菊花时常瘙痒、疼痛
坐下如针扎
走路摩擦到
疼的面红耳赤!

长在里面的叫内痔
上厕所一用力
肉球就会脱出
严重时,上厕所全是血
甚至还要用卫生巾,又疼又尴尬

平时用纸擦个屁股
像是砂纸在伤口上摩擦
简直就是是“刮骨疗伤”!

痔疮虽然不算什么大病
但是长期不理会
轻则贫血、四肢乏力
头晕脑胀,睡不好觉
重则会导致直肠炎性增生
引发直肠癌等重大隐患
严重时还会危及性命!

俗话说:“十人九痔”
痔疮不分年龄、不分性别
一旦患上,反反复复,很难断根!

不瞒大家
小编一年前也是
被无数痔疮膏、拴
折磨了两三年
有时卫生纸擦痔疮
屁屁痛到抽畜、血染菊花...

于是我每天上完厕所后
改用了一款专门擦屁屁的湿巾
【败败火抑菌湿巾】

当初仅是为了
让自己擦屁屁时舒服少受罪
没想用了一个多月后
脱垂的痔疮
竟然神奇的回缩、消失了!

别小看这一片小小的痔清湿巾
上完厕所后,简单一擦
把肛周污毒清洁带走同时
将龙血竭等
活血化瘀、去腐生肌的神奇成分
在病灶充分覆盖吸收

一般用两盒
不用切、不用涂、不用塞
轻轻松松摆脱痔疮的烦恼

找到外清洁、内xiu复
好用且效果不错的痔疮湿巾
首要就是分享给我亲近的人
↓↓↓
我姑妈私下偷偷向我要了2盒
她因为痔疮
时常痛得连坐都没法坐
4年里去割了3次
还是老复发...

开始用败败火痔清湿巾以后
当天就不痛不痒了
头一天就觉得怎么坐都不痛了
2个月后去做了肛门镜检查
痔疮竟然不见了
到现在也没再难受


1
简单一擦,不疼痛、不出血
这款败败火痔清湿巾
效果为何这么强大?
关键在于它的黄金成分——龙血褐

龙血树平均年龄八千年
砍下皮会出现血红的汁液
名为龙血褐
千百年来都是傣族的“神药”。

中医认为:
它有活血散瘀,定痛止血
敛疮生肌之效

龙血竭
即可活血,又可止血
既能消痔疮内部的瘀滞
又能让痔疮不出血
让疼痛坠痛感消失

北京大学第三医院王副主任
就曾表示:
现代医学治痔疮
止血、活血排脓的话
也是会选龙血竭

而且湿巾还有
北美金缕梅、苦参等抑菌成分
在肛肠粘膜形成保护膜
防止病原微生物繁殖
内活血化瘀+外清湿毒
内外兼施、标本兼顾,不反复

有痔疮,千万不能拖!
早用早健康,早预防早受益!
尤其适合以下几类症状人群~

用过的朋友都积极反馈:
▼
@秋风凉:
用这个痔清湿巾
感觉像是打开了新世界的大门
清清凉凉,现在痔疮好了很多
不流血了也不痛不痒了!
办公室坐一整天都没事

@一米阳光:
自从用了这个痔清湿巾
灼热 感消失了
现在不痛不便血,痔疮好多了!
过一短时间去医院检查
肉球竟然消失了
再也不用忍受反复折磨了


2
直击病灶,“痔”在必除
这款败败火痔清湿巾
参透率高,吸收快,药效强
擦拭患处,3秒清凉
立马降低痔疮带来的
火烧感、疼痛感!

相较于传统的膏药、栓剂
它浓缩了10倍草本精华
能更全面的参透到痔核细胞
隔离其生长和增殖的基因信号

遵循“君臣佐使”科学配方
多一分则溢,少一分或缺
标本兼顾!

连续使用一段时间
外痔小疙瘩就会逐渐消失
脱垂的内痔小肉球
也慢慢地缩回去并变小

“湿敷”,让体内的热毒消散
疏通血瘀,解决痔疮“源头”
烦恼不再反反复复!


3
一擦洁净,止痒抑菌去湿毒
传统的痔疮膏、栓剂
都不能及时带走肛垫四周的脏污
病原维生素粘在肛周
入侵肛垫导致痔疮反反复复~

所以,想要除痔疮
除了要消散热毒
更要及时清洁肛周
不给细菌、病原可乘之机!

北美金缕梅抑菌舒缓
苦参消炎;蒲公英清热解毒

轻轻一擦
将脏污全部带走
还给屁屁来一个全方面消毒
给肛周创造一个
洁净、舒爽的环境!

经权威机构检测:
它能杀灭99%的菌
包括念珠杆菌、葡萄球菌、大肠杆菌等

在显微镜下
我们不难看出
使用败败火痔清湿巾后
痔核细菌减少了很多!
而且相比于普通纸巾来说
湿巾清洁力更强!
不是那种湿哒哒的
而像拧干的湿毛巾
不用大力摩擦
轻轻松松将褶皱里污垢“拽”出来。

看下这对比
就知道为什么要选择痔清湿巾了!
这下连洗屁股的环节都省了~

一段时间后
无论是外痔的疙瘩
还是内痔的肉球
都慢慢缩小、干瘪,不再外脱
肛内环境洁净
做到从源头解决!

包装非常具有私密性
一盒16片
独立包装、小巧便携
随时放身上
都能解决你的燃眉之急!
建议使用5盒以上效果更佳~

